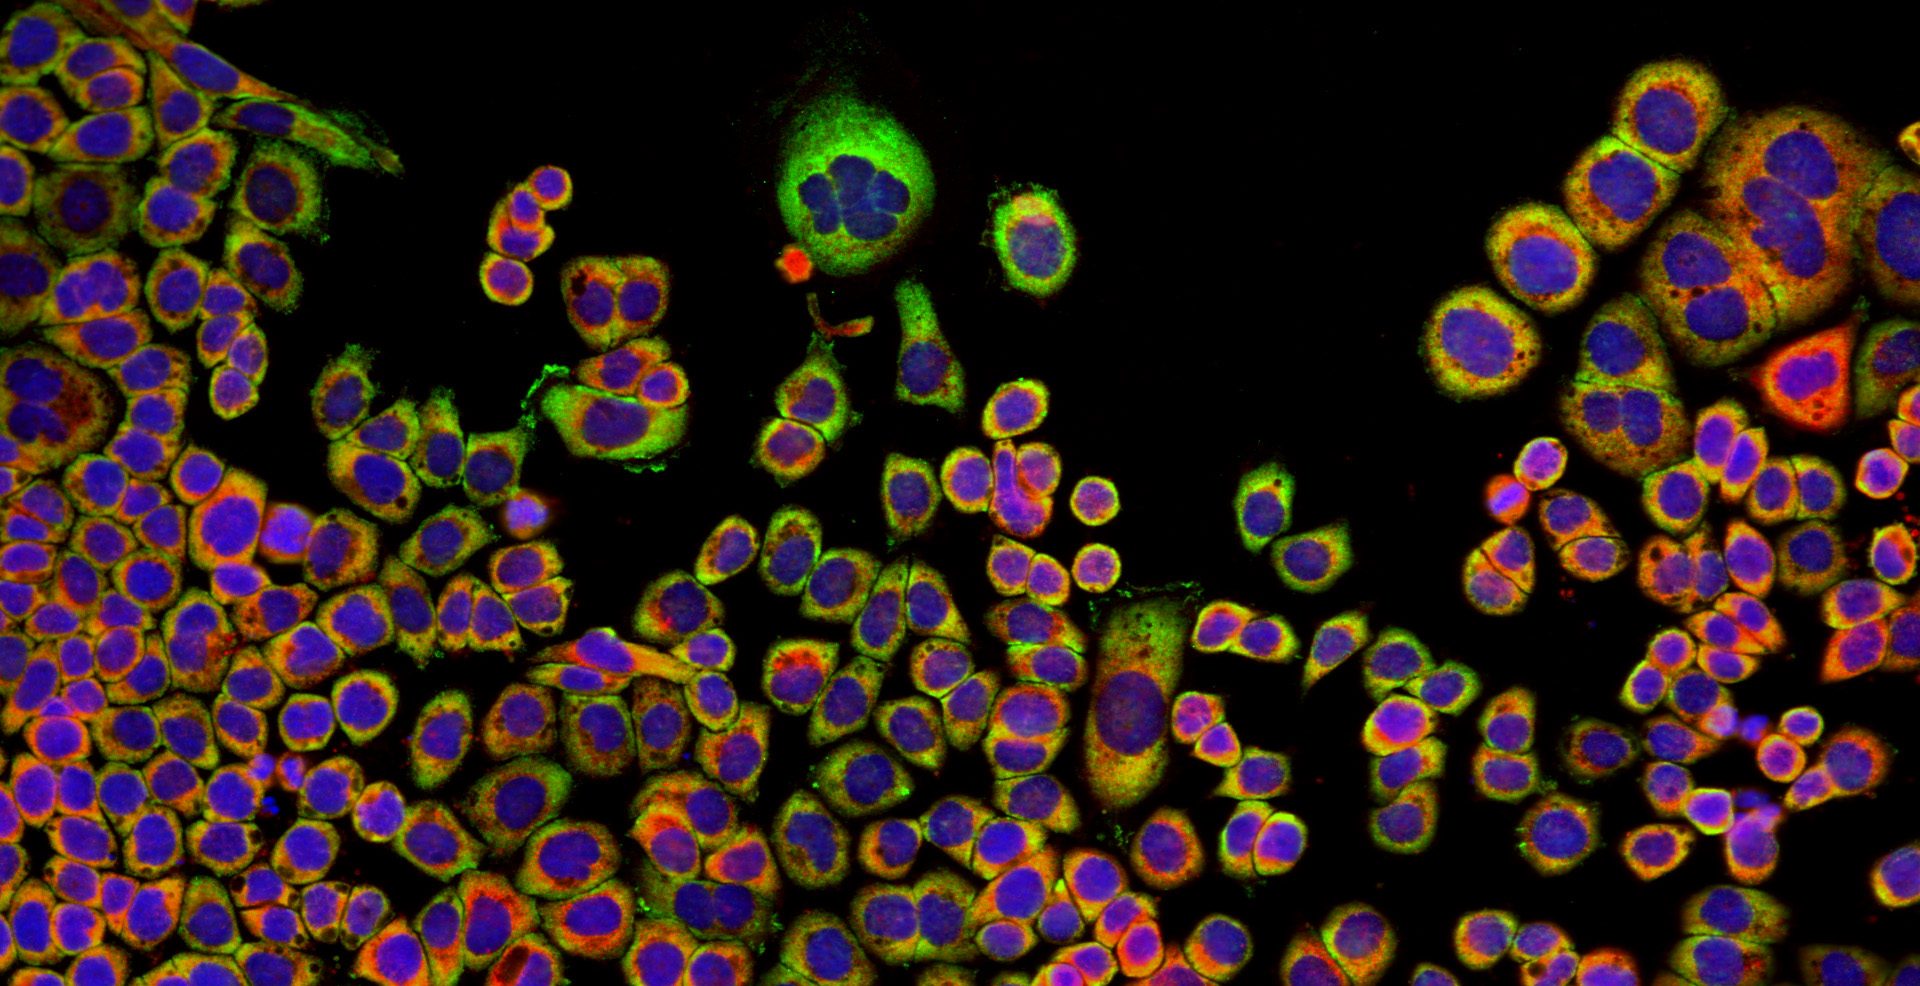

Mile End Hospital was opened in 1883 on the site of a former workhouse and became a nurse training school in 1892. Facilities at the hospital greatly improved as a result of military occupation in the First World War.
The hospital is located in the Mile End area of the London Borough of Tower Hamlets. It joined Barts Health NHS Trust in 2012.
There are a range of outpatient services at Mile End Hospital for people with chronic conditions, along with the early detection and treatment of cancer and other conditions. Mile End also hosts a number of other health services. It is home to sports medicine research and training facilities for our academic neighbours at Queen Mary University of London.
Projects we have funded at Mile End Hospital include creation of a dedicated kidney dialysis centre to provide a “home away from home” environment for kidney patients; and a state-of-the-art 3T MRI scanner to help spot cancer sooner.